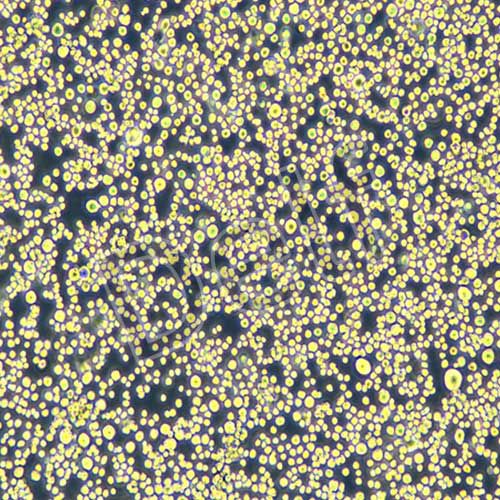

MC3T3-E1Subclone 14 小鼠顱頂前骨亞克隆14
目錄價(jià)
¥ 1400.00
 一鍵復(fù)制產(chǎn)品信息
一鍵復(fù)制產(chǎn)品信息
別稱(chēng)Subclone 14 of mouse anterior cranial bone;MC3T3-E1Subclone 14
貨號(hào)Delf-10343
規(guī)格
細(xì)胞特性貼壁生長(zhǎng)
形態(tài)成纖維細(xì)胞樣
來(lái)源小鼠;顱頂骨
傳代比例1:2傳代
用途僅供科研使用
推薦培養(yǎng)基 MC3T3-E1Subclone 14 專(zhuān)用培養(yǎng)基
產(chǎn)品推薦
聯(lián)系方式
- 電話:400-1016-218
- 郵箱:355185756@qq.com
- 地址:安徽省合肥市高新區(qū)黃山路602號(hào)合肥國(guó)家大學(xué)科技園A401室
產(chǎn)品詳情
|
一、細(xì)胞簡(jiǎn)介 |
|
|
細(xì)胞簡(jiǎn)介 |
從克隆的但是表型各異的MC3T3-E1細(xì)胞系中分離出一系列亞克隆。 從含抗壞血酸培養(yǎng)基生長(zhǎng)的成骨細(xì)胞中選擇高或低成骨細(xì)胞分化、礦化的亞克隆。 MC3T3亞克隆4(ATCC CRL-2593)和MC3T3亞克隆14(ATCC CRL-2594)在抗壞血酸和3到4mM無(wú)機(jī)磷酸鹽中生長(zhǎng)表現(xiàn)出高水平的成骨細(xì)胞分化。 它們10天后形成一個(gè)礦化良好的細(xì)胞外基質(zhì)(ECM)。 MC3T3亞克隆24(ATCC CRL-2595)和MC3T3亞克隆30(ATCC CRL-2596)在抗壞血酸中生長(zhǎng)表現(xiàn)出很差的成骨細(xì)胞分化。 不形成ECM, 可以作為亞克隆4和14的陰性對(duì)照。 礦化的亞克隆選擇的表達(dá)作為成骨細(xì)胞標(biāo)記的mRNA,及唾液酸糖蛋白(BSP),骨鈣素(OCN),和甲狀旁腺激素/甲狀旁腺激素相關(guān)蛋白受體的mRNA。 高或者低的分化潛能的亞克隆在培養(yǎng)中生產(chǎn)出相似數(shù)量的膠原質(zhì),表達(dá)可比較的基本水平的mRNA編碼Osf2/Cbfa1,一種成骨細(xì)胞相關(guān)轉(zhuǎn)錄因子。 植入免疫缺陷小鼠以后,高分化性的亞克隆形成與骨類(lèi)似的形成小骨的編織骨,低分化細(xì)胞只是產(chǎn)生纖維組織。 這些細(xì)胞系是研究體外成骨細(xì)胞分化的好模型,尤其是ECM信號(hào)。 它們和原代培養(yǎng)顱頂成骨細(xì)胞的行為類(lèi)似。 |
|
細(xì)胞名稱(chēng) |
MC3T3-E1Subclone 14 小鼠顱頂前骨亞克隆14 |
|
細(xì)胞別稱(chēng) |
MC3T3-E1SUBCLONE14 |
|
細(xì)胞貨號(hào) |
Delf-10343 |
|
來(lái)源 |
小鼠;顱頂骨 |
|
細(xì)胞形態(tài) |
成纖維細(xì)胞樣 |
|
生長(zhǎng)特性 |
貼壁生長(zhǎng) |
|
培養(yǎng)條件 |
MEMα培養(yǎng)基;特級(jí)胎牛血清+10%;P/S+1%; |
|
培養(yǎng)環(huán)境 |
氣相:空氣,95%;二氧化碳,5%。 溫度:37℃,培養(yǎng)箱濕度為70%-80%。 |
|
二、細(xì)胞復(fù)蘇方法 |
|
|
復(fù)蘇步驟 |
1、將凍存管在37℃水浴中迅速搖晃解凍; |
|
三、細(xì)胞傳代方法 |
|
|
傳代比例 |
1:2(具體情況視細(xì)胞生長(zhǎng)速度及密度決定) |
|
傳代方法 |
1、盡量吸干凈T25瓶原培養(yǎng)基; |
|
注意事項(xiàng) |
不同品牌胰酶消化時(shí)間差別較大,可根據(jù)細(xì)胞形態(tài)判斷消化進(jìn)程 |
|
四、細(xì)胞凍存方法 |
|
|
凍存液配方 |
凍存液:90%血清,10%DMSO,現(xiàn)用現(xiàn)配(推薦使用DELF無(wú)血清非程序細(xì)胞凍存液Delf-16090進(jìn)行凍存細(xì)胞,快速,便捷)。 |
|
凍存規(guī)格 |
按每1ml凍存液含1×106~1×107個(gè)活細(xì)胞/ml分配到一個(gè)凍存管中將細(xì)胞分配到凍存管中,標(biāo)注好名稱(chēng)、代數(shù)、日期等信息。 |
|
凍存方法 |
1、消化并離心收集細(xì)胞,計(jì)數(shù),推薦凍存密度為1×106~1×107個(gè)活細(xì)胞/ml; |
|
五、注意事項(xiàng) |
|
|
注意事項(xiàng) |
1、所有動(dòng)物細(xì)胞均視為有潛在的生物危害性,必須在二級(jí)生物安全臺(tái)內(nèi)操作,并請(qǐng)注意防護(hù),所有廢液及接觸過(guò)此細(xì)胞的器皿需要滅菌后方能丟棄。 2、建議在復(fù)蘇凍存細(xì)胞時(shí)始終使用防護(hù)手套、衣服和戴上防護(hù)面罩。注意:凍存管浸沒(méi)在液氮中會(huì)泄漏,并會(huì)慢慢充滿(mǎn)液氮。解凍時(shí),液氮轉(zhuǎn)化成氣相可能導(dǎo)致容器爆炸或用危險(xiǎn)力吹掉其蓋子,從而產(chǎn)生飛揚(yáng)的碎屑造成人員傷害。 3、本產(chǎn)品僅限于科學(xué)研究,絕不可作為動(dòng)物或人類(lèi)疾病的治療產(chǎn)品使用。 |
STR鑒定



常見(jiàn)問(wèn)題
答:公司提供兩種運(yùn)輸方式供老師選擇,1、復(fù)蘇的活細(xì)胞:采用常溫發(fā)貨的方式,收到即可觀察密度并判斷是否進(jìn)行傳代操作。優(yōu)勢(shì)是省去復(fù)蘇的步驟,細(xì)胞成活率較高。2、凍存的細(xì)胞:采用干冰運(yùn)輸,一般情況下發(fā)貨是2支凍存管,收到后放-80過(guò)夜,第二天轉(zhuǎn)入液氮長(zhǎng)期存儲(chǔ),擇機(jī)復(fù)蘇。優(yōu)勢(shì)是發(fā)貨快,一般一兩天即可收到,缺點(diǎn)是需要自己復(fù)蘇。
答:我公司提供的細(xì)胞大部分都參考資源庫(kù)的培養(yǎng)信息,如ATCC、DSMZ、中科院等等官方平臺(tái)。也有少部分細(xì)胞為客戶(hù)提供了替代培養(yǎng)方案,根據(jù)客戶(hù)的意愿進(jìn)行選擇!
答:不可以重復(fù)使用,一般從我公司發(fā)出的細(xì)胞都需要達(dá)到一定的密度后發(fā)出,充液的培養(yǎng)基血清比例會(huì)比正常培養(yǎng)時(shí)所用到的培養(yǎng)液低很多,通常在3-5%,以維持細(xì)胞存活,控制生長(zhǎng)速度,不可以用來(lái)做細(xì)胞培養(yǎng)使用。
答:細(xì)胞在鏡下發(fā)現(xiàn)圓形的白色的點(diǎn)點(diǎn),一般情況下是為貼壁的細(xì)胞或脫落的細(xì)胞死亡后的產(chǎn)物,懸浮細(xì)胞也會(huì)有這種現(xiàn)象,出現(xiàn)圓形的光圈一樣的圓點(diǎn)。通常,白色的圓點(diǎn)是分散分布的,聚團(tuán)類(lèi)的懸浮細(xì)胞可能會(huì)聚團(tuán)出現(xiàn)白色的亮斑,技術(shù)老師可以繼續(xù)培養(yǎng)并觀察。
答:一般情況下,我公司建議客戶(hù)收到細(xì)胞后傳1-2代后即可安排凍存留種,可先凍存1-2支凍存管,凍存的細(xì)胞數(shù)量多一些,便于后期復(fù)蘇。購(gòu)買(mǎi)原代細(xì)胞的客戶(hù),要充分考慮該細(xì)胞的傳代次數(shù)限制,人源原代細(xì)胞大概可以傳7代左右,鼠源的可以傳3代左右,對(duì)于一些能傳代次數(shù)很少的原代細(xì)胞,不建議凍存,收到后調(diào)整狀態(tài)后即可安排實(shí)驗(yàn)。

皖公網(wǎng)安備 34010402703761號(hào)
皖公網(wǎng)安備 34010402703761號(hào)





 方經(jīng)理:355185756
方經(jīng)理:355185756














